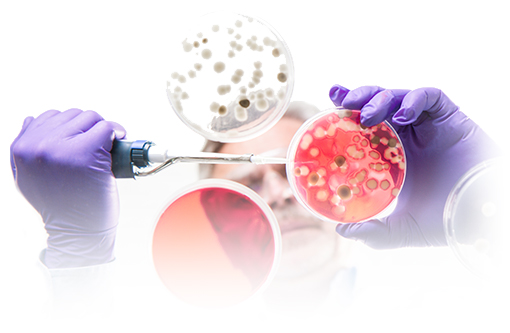

Moving Medicine Forward
The University of Rochester Medical Center (URMC) is home to more than 3,000 people dedicated to scientific research, studying common and rare illnesses, from cancer and heart disease to Parkinson’s and RSV. These efforts have led to therapies that have saved countless lives and improved human health locally, in the region, and across the globe.
Over the last five years, URMC has garnered more than $1.3 billion in biomedical research funding. Coupled with state-of-the-art research space, and high-end support services and shared resources, we’re building upon this strong legacy of research every day.


